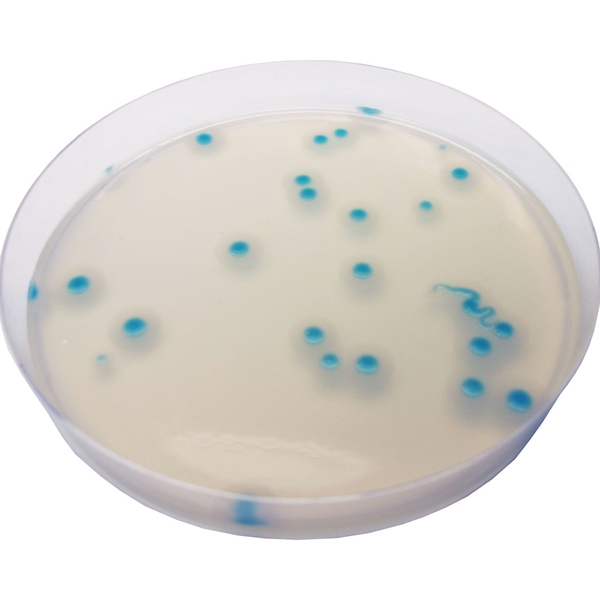
CHROMagar™ B. cereus
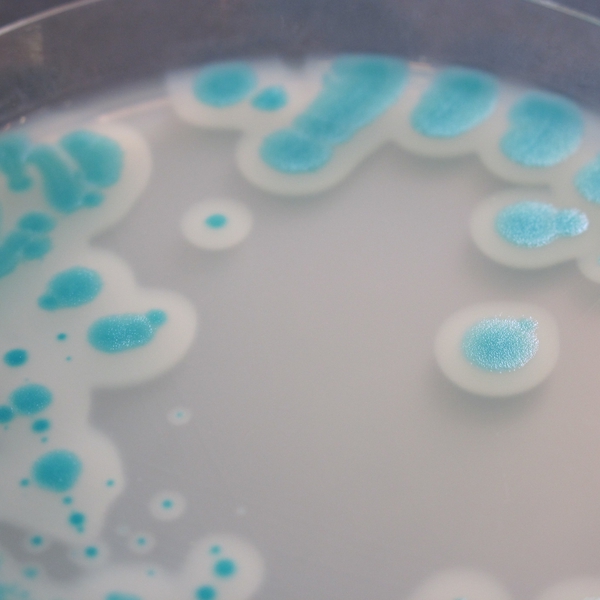
CHROMagar™ B. cereus

Colonies Appearance
Performance
Performance
Bacillus cereus is a spore-forming bacterium that can be frequently isolated from soil and some food and which produces toxins. These toxins can cause two types of illness: one type characterized by diarrhea (long incubation, 8-16 hours) and the other by nausea and vomiting (short incubation, 1-6 hours).
The short-incubation form is most often associated with rice dishes that have been cooked and then held at warm temperatures for several hours.
Long-incubation B. cereus food poisoning is frequently associated with meat or vegetable-containing foods, after cooking. The bacterium has been isolated from dried beans and cereals, and from dried foods such as spices, seasoning mixes and potatoes.
The short-incubation or emetic form of the disease is diagnosed by the isolation of B. cereus from the incriminated food. The long-incubation or diarrheal form is diagnosed by isolation of the organism from stool and food.
1. Easy Reading after only 24 h : 24 h incubation at 30 °C. The intense blue colored colonies on a translucent agar facilitates the reading compared to Mannitol based agar which displays red colonies on pink agar.
4. Highly sensitive & specific for cereus group compared to MYP or Mossel agar.
The classical MYP or Mossel agar rely on the inhabilité of B. cereus to use the mannitol, which renders the plate reading difficult in the presence of abundant flora. CHROMagar™ B.cereus, due to the chromogenic technology, overcomes this difficulty.
2. Simplicity : Contrary to MYP or Mossel agar, there is no need to add the egg yolk emulsion.
5. Longer prepared plate shelf-life compared to MYP and Mossel agar which only have a 5 days shelf-life.
3. Better selectivity & recovery compared to classical media compared to classical medium agar.
* Specificity and sensitivity from Scientific Study: Adria Normandie Study, 2012.
Composition

Technical Documents
Scientific Publications
2022
Performance Testing of Bacillus cereus Chromogenic Agar Media for Improved Detection in Milk and Other Food Samples
📄 Publication2012
The evaluation of chromogenic medium for quantitative analysis of B.cereus in Korean traditional sauce
📄 Publication

Read more